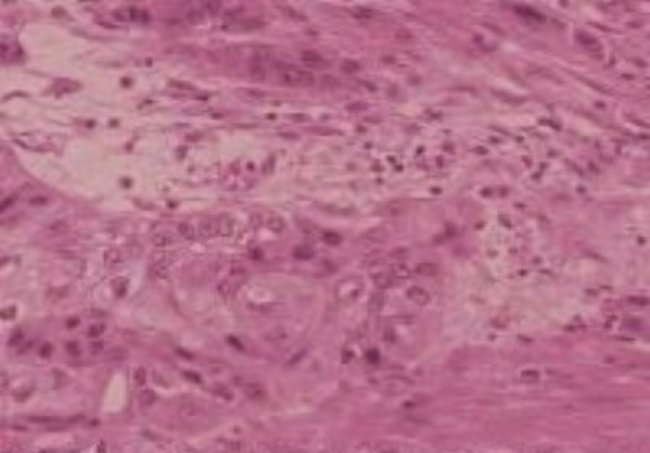

Human Various Tissue Microarray (Cancer) Slide, Used In Common Research Applications Such As Immunohistochemistry-Paraffin, Each
$ 348.41
|
|
Details:
Formalin fixedTissue condition: CancerSpecies: HumanCross reactivity: HumanCore diameter: 2.0mmSection thickness: 4µmRecommended StorageStore at 4°C. Do not freeze.Warranty and Services1 Year
Additional Information
| SKU | 10501131 |
|---|---|
| UOM | Each |
| UNSPSC | 41123201 |
| Manufacturer Part Number | NBP230331 |
